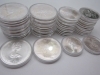
カナダモントリオールオリンピック記念銀貨

マイストア
変更
お店で受け取る
(送料無料)
配送する
納期目安:
2025.12.20 6:18頃のお届け予定です。
決済方法が、クレジット、代金引換の場合に限ります。その他の決済方法の場合はこちらをご確認ください。
※土・日・祝日の注文の場合や在庫状況によって、商品のお届けにお時間をいただく場合がございます。
カナダオリンピック記念銀貨 2枚セット 1976年 カナダ モントリオール オリンピック 記念 銀貨 28枚セットの詳細情報
1976年 カナダ モントリオール オリンピック 記念 銀貨 28枚セット。カナダモントリオールオリンピック記念銀貨。オリンピック モントリオール大会記念銀貨 カナダ モントリオール。の状態については、台紙を開けることはできないので、写真をご覧ください。長期自宅保管のため、経年劣化や保管過程での傷は確実にあります。神経質な方はご遠慮ください。バラ売りの場合、それぞれ8100円です。。カナダオリンピック 1976 記念銀貨 セット。ただ、写真に写りきっていない傷、汚れはあると思ってください。純銀製 鉄道開業百年記念 日本国有鉄道100年メダル昭和47年。【御確認用】純銀メダル●マグマ大使 監修/手塚プロダクション ●鉄腕アトム。袋かダンボール等の箱にプチプチ等で包んで発送します!それでもいい方のみよろしくお願いします。天皇陛下御即位大礼記念 奉祝記念メダル。プルーフ天皇陛下御在位60周年記念1万円銀貨。状態は写真をご覧ください。中日ドラゴンズ 純金カレンダー。安政丁銀 160.9g 桐箱あり。ご希望の方、コメント下さい。2023年 ウイーン フィルハーモニー 銀貨10セット
ベストセラーランキングです
近くの売り場の商品
カスタマーレビュー
オススメ度 4.7点
現在、6787件のレビューが投稿されています。